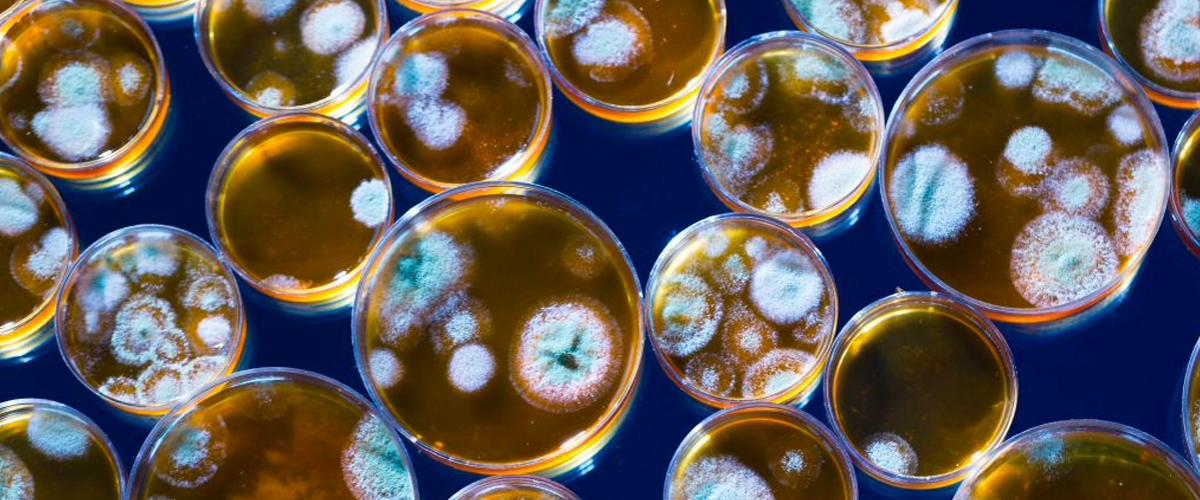
TODO:

Считается, что аллергия на пенициллин есть у каждого десятого человека. Из-за аллергии врачи обычно назначают альтернативные антибактериальные препараты широкого спектра действия, которые менее эффективны при определенных инфекциях. Между тем только 5% пациентов имеют сильную аллергию на пенициллин, для 95% он безопасен. В новом исследовании ученые стремились разработать простую систему оценки для выявления реальной аллергии и реакций с низким риском опасности. Выводы опубликованы на сайте Университета Макглилла.
Диагностическую процедуру назвали PEN-FAST. По словам автора исследования Джейсона Трубиано, она поможет более чем 90% аллергикам использовать пенициллин без опасений за реакцию организма.
Сегодня для оценки аллергической реакции выполняется кожная проба. В рамках исследования 382 участника были распределены либо в группу кожной пробы с последующим пероральным введением пенициллина, либо в группу только прямого перорального введения препарата. Эксперимент показал, что оба метода одинаково эффективны — только у одного человека из каждой группы была положительная реакция на лекарство.
Важно, что ни у кого из участников не отмечено побочных эффектов и других нежелательных явлений. Результаты демонстрируют, что подавляющее большинство людей, которым в детстве сообщили об аллергии на пенициллин, на самом деле могут безопасно использовать этот антибиотик при наличии показаний. Для пациентов это означает более целевое и эффективное лечение, поскольку альтернативные антибиотики широкого спектра действия часто приводят к развитию резистентности и не всегда дают нужный терапевтический результат.
Ранее ученые из США представили универсальный подход к лечению аллергии. Они обнаружили новую мишень, которая может изменить классическую стратегию лечения.